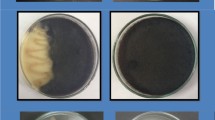

Abstract
Biological control with microorganisms is regarded as a promising control strategy against Botrytis bunch rot (BBR, grey mould) on grapes. Candida sake CPA-1 is a yeast that has previously shown a high efficacy against BBR in small-scale field trials. The present work aims to confirm this efficacy in commercial conditions and to evaluate the compatibility of C. sake with phytosanitary products that are commonly used in viticulture. The large-scale spray programmes (two to three applications in the growing season) were carried out in three field sites in Catalonia, North-East Spain, with different vineyard management styles. The overall reductions were in the ranges of 35 ± 5.7 to 64 ± 3.7% incidence, and 39 ± 17.5 to 85 ± 3.9% severity, compared to the control. Only four out of 39 phytosanitary products, tested in liquid suspension with C. sake, were incompatible with the yeast. The results demonstrated the potential of C. sake to become a reliable solution as a biocontrol product to be integrated in the control of BBR within the future.
Similar content being viewed by others
Avoid common mistakes on your manuscript.
Introduction
Botrytis bunch rot (BBR) represents one of the main fungal diseases of grapevine and the most frequent bunch rot of grapes, causing quantitative and qualitative losses in pre- and post-harvest of grapes and other fruit crops (Ky et al. 2012; Romanazzi et al. 2016). Botrytis cinerea Pers.: Fr is the necrotrophic pathogen causing this disease. It infects host green tissues and also is able to perform saprophytic colonisation of senescent and necrotic host tissues, which generates diversity in primary and secondary inoculum sources (Calvo-Garrido et al. 2014c), conforming to a complex life cycle, particularly in vineyards (Elmer and Michailides 2004). Another characteristic of this fungal pathogen is its ability to easily develop resistance to synthetic fungicides, as reported by numerous studies (Fillinger and Walker 2016; Walker et al. 2013). Therefore, the use of synthetic fungicides to control BBR on grapes is becoming a less attractive strategy, in addition to having other drawbacks that are related to environmental and human health impacts and wine quality (Cus et al. 2010; Oliva et al. 1999).
Biological control of BBR with microbial antagonists is regarded as a suitable alternative to fungicide use and many research groups worldwide have investigated the efficacy of different strains of antagonistic bacteria, yeast, yeast-like fungi and filamentous fungi against B. cinerea, in laboratory and small-scale field experiments (Elmer and Reglinski 2006; Romanazzi et al. 2016). However, BBR reduction in the field is usually variable and few biological control agents (BCAs) make it to the last steps of product registration, including large-scale field experiments as well as compatibility tests (Köhl et al. 2011).
In this context, there are few reports of large-scale experiments dealing with BCA control of Botrytis-related diseases in strawberry (Freeman et al. 2004) or post-harvest of stone fruit (Karabulut and Baykal 2003). The only study on large-scale BBR control with alternative methods in grapevine, to the best of our knowledge, refers to the application of salts (Nigro et al. 2006). These important steps regarding research are crucial to the eventual development of a commercial product and are rarely accomplished, according to the reduced number of registered BCA products for BBR control in vineyards. Nonetheless, large scale trials are rarely published because this information is under the auspices of the trade secrets policies of commercial companies during product development.
Candida sake CPA-1 is a biocontrol yeast that is effective against B. cinerea and other important diseases of pome fruit. It was commercialised by demand, during a short period of time, for its use in post-harvest storage as the commercial product Candifruit® (Teixidó et al. 2011). The same C. sake isolate has already been tested against BBR in the field, and applied with the fatty acid-based product Fungicover® (FC), with exceptionally good results during different growing regions in Spain and France (Calvo-Garrido et al. 2013, 2014b; Cañamás et al. 2011). The observed efficacy has encouraged advancement towards the stage prior to product registration and, likewise, corroborate that C. sake might meet the need of growers for reliable BCA solutions, that could be applied under a wide range of growing conditions and easily implemented in the field. Hence, the aims of this work are to confirm the efficacy of C. sake plus FC treatments in commercial conditions with a variety of vineyard management practices and climatic conditions, as well as to test the compatibility of the BCA with phytosanitary products that are commonly used in viticulture, looking forward to future integration of this yeast in IPM control strategies against BBR.
Materials and methods
Experimental vineyard sites
Three different vineyards in Catalonia, in the North-East of Spain, were used in the field experiments during the growing season of 2011. Two of the vineyards (Vineyard 1 and Vineyard 2) were managed with integrated pest management (IPM) strategies and were located in the Designation of Origin Penedés, subzone Penedés Central. The third vineyard (Vineyard 3) was conventionally managed and located in the southern sector of the Designation of Origin Costers del Segre, subzone Vall del Riu Corb. According to the 30-year climatic series (1971–2000), elaborated by the Meteorological Service of Catalonia, the Penedés region has a southern coastal Mediterranean climate that is modulated by the proximity of the sea. Annual precipitation values are around 550 mm, with mild winter (Mean T = 6–8 °C) and hot summer (Mean T = 23–24 °C) (Climatologia 2009a). The Costers del Segre region is characterised by a dry so-called Mediterranean-continental climate, with higher thermal amplitude and lower RH. Mean temperature in winter is in the ranges of 3.5–6.5 °C and 20–25.5 °C in the summer months, whereas annual precipitation is 428 mm (Climatologia 2009b).
Grape cultivar in all of the three field sites was Macabeo (or Macabeu), which is a cultivar susceptible to BBR due to the characteristic large and compact clusters (Fuster 2006). In Vineyard 1, vines were high-trained on wires and in untilled soil, while in Vineyard 2 and Vineyard 3 the training was on a traditional gobelet (goblet) system and with tilled soil.
C. sake CPA-1 production and formulation
The strain CPA-1 of C. sake is deposited in the Colección Española de Cultivos Tipo (CECT-10817) at the University of Valencia, Burjassot, Spain. C. sake was used for experiments as a formulated product that was developed in the IRTA research centre located in Lleida (Catalonia, Spain), following cell production and formulation methods as described by Cañamás et al. (2011). After formulation, the cell suspension was stored at 5 ± 1 °C prior to field application. C. sake was always applied with the natural fatty acid-based product Fungicover® (Biodúrcal S.L., Granada, Spain), which has shown in previous studies to improve C. sake survival and also to have some antibotrytic activity (Calvo-Garrido et al. 2014a, d).
Experimental design and field treatments
In this large-scale field trial, the experimental design was similar for each of the three vineyards, and included three plots of 0.5 ha each, that were distributed in a homogeneous part of the commercial vineyard. Each plot corresponded to one of the treatments. Inside each treatment plot, six subplots were randomly distributed and used as replicate samples for assessment of BBR and quantification of C. sake populations in the surface of grapevine tissues. Each of these subplots consisted of ten adjacent vines in the same row.
The treatments were: Untreated control; High dose: C. sake 2.5 × 107 Colony Forming Units (CFU) ml−1 + FC 50 g l−1; Low dose: C. sake 1 × 107 CFU ml−1 + FC 25 g l−1. Treatments consisted of two applications at early-season key phenological stages (80% flowering and pre-bunch closure), plus an optional late-season application (from veraison to commercial harvest) in case of hail or heavy rain episodes during the fruit ripening period. This strategy, based on two applications only, is justified by previous studies that show high efficacy of early-season treatments with C. sake in vineyards (Calvo-Garrido et al. 2013).
The application was carried out by the vineyard technicians, using motorised sprayers that were hitched to a tractor, in applying approximately 300–400 l ha−1 of the treatment mixture. The sprayer and tractor were the equipment that was usually employed in the commercial vineyard by the local manager, and the equipment was different for each field site.
At commercial harvest dates, BBR incidence (% of bunches with BBR symptoms) and severity (% of berries with BBR symptoms in each bunch) were assessed over 50 bunches per replicate subplot. Commercial harvest dates were 24/08/2011, 01/09/2011 and 15/09/2011 for vineyards 1, 2 and 3, respectively.
C. sake CPA-1 population dynamics on grapevine tissues
The populations of C. sake CPA-1 on grapevine flowers or developing berries were quantified during the field experiment. Tissue samples were collected just after spray applications, at different times between applications (depending on the field site), and at harvest. The methodology that was followed for sample collection, sample washing, serial dilutions and colony counting was as described by Calvo-Garrido et al. (2013). Population levels on grape tissues were expressed as CFU per sample gram.
In vitro compatibility of C. sake with pesticides commonly used in viticulture
Different phytosanitary products (fungicides, insecticides and wetting agents) that are commonly used in Spain against grapevine diseases and pests, were evaluated in order to observe their effects on C. sake cells after contact. In these in vitro assays, solutions (50 ml, three replicates) of a single product or a combination (Table 1) were prepared, at the field application dose, as recommended by the manufacturer, in order to more easily evidence a hypothetical toxic effect of the product. Then, a concentrated C. sake cell suspension was added, adjusting to a final concentration of 2.5 × 108 CFU ml−1. After 30 min of continuous shaking to allow contact between C. sake cells and the product, a 1 ml aliquot was taken and diluted 10X, in order to minimise contact after this point. A control treatment with no product was included for every test. Replicate samples were taken just after the addition of C. sake cells (0 min; control) and after 30 min of exposure to products (control and treatments). Aliquots were serially diluted and plated (NYDA medium: nutrient broth, 8 g l−1; yeast extract, 5 g l−1; dextrose, 10 g l−1; and agar, 15 g l−1). C. sake colonies were counted after 48 h of incubation at a temperature of 25 ± 1 °C in the dark. The C. sake cell concentration in the control and the treatments (CFU ml−1), at the 30 min sampling, were then compared in order to observe hypothetical significant reductions due to contact with phytosanitary products.
In vivo compatibility of C. sake with pesticides commonly used in viticulture
After the in vitro evaluation, three products were characterised as fully incompatible (see results section). However, the toxicity of these products for C. sake may be lower if the product is already in grapevine tissues before C. sake establishment, allowing the use of both strategies by providing a time lapse between applications. This effect was tested on mature Macabeo (Macabeu) berries. Each of the two fully incompatible products (F14 and F29) were applied to four grape clusters of five berries, which were considered as a replicate. Each treatment consisted of four replicates. A set of four replicates with no fungicide application was considered as the control treatment. After a fungicide application by immersion in water solutions of the products during 30 s, clusters were air dried for 2 h and stored at temperatures of 20 ± 1 °C and 50 ± 5% RH. Then, after 0, 24, 96 or 168 h of storage time after application (TAA), the treatment and control clusters were immersed in a C. sake suspension (C. sake CPA-1 at 5 × 107 CFU ml−1 + FC 50 g l−1). Clusters were air dried for two hours and then C. sake populations were recovered and quantified, as described above, for assessment of population dynamics on grapevine tissues.
In vivo compatibility of C. sake with Bacillus thuringiensis var. kurstaki
An in vivo test on grape berries was conducted in order to evidence a possible antagonistic effect between C. sake and B. thuringiensis (BT), a bacterium commonly used as a BCA against grape berry moth. Four replicates consisting of four grape clusters (five berries each) were treated with C. sake alone (CS; C. sake CPA-1 at 5 × 107 UFC ml−1 + FC 50 g l−1), or BT and after two hours of air drying CS (BT + CS; B. thuringiensis at 5.55 × 106 CFU ml−1 and then C. sake CPA-1 at 5 × 107 UFC ml−1 + FC 50 g l−1). Treatments were applied by immersion in the corresponding suspensions. After treatment, clusters were incubated at 20 °C and 80% RH, and populations of the bacteria or yeast were recovered after 0, 24, 96 or 168 h of incubation, following the methodology that was described in the previous section. Plating of BT + CS samples to observe B. thuringiensis colonies was carried out on NYDA medium, whereas NYDA medium with streptomycin sulphate (0.5 g l−1) was used to evaluate C. sake populations (CS and BT + CS). BT colonies were counted 24 h after incubation at 25 ± 1 °C and C. sake colonies were counted 48 h after incubation at 25 ± 1 °C, according to the corresponding colony morphology.
Statistical analysis
The effect of treatments on BBR in the field experiments was analysed using a Generalised Linear Model (binomial distribution; logit link function), based on the frequencies of infected bunches or berries, and evaluated bunches or the total number of berries per bunch, for incidence and severity, respectively. Mean separations within a factor were performed by orthogonal contrasts. Differences among C. sake populations, in vitro or in vivo, were explored by analysis of variance (ANOVA). The Tukey test was employed for comparing mean C. sake populations within treatments. Notwithstanding, C. sake populations, expressed in CFU, were log transformed prior to ANOVA. All analyses were performed with JMP®Pro12 software (SAS Institute, NC, U.S.A.)
Results
Efficacy of C. sake large-scale applications in commercial vineyards
The results from each vineyard location are presented separately (Figs. 1a–c). In the untreated control, BBR incidence and severity was 52.3 ± 6.9 and 9.7 ± 2.6%, 49.3 ± 2.6 and 5.9 ± 0.5%, 57.0 ± 1.7 and 8.6 ± 0.7, for field sites one, two and three, respectively. Significant differences among treatments were detected in the three field sites. In Vineyard 1 (Fig. 1a), both treatments with C. sake plus FC (high dose and low dose) significantly reduced the incidence (df = 1; χ2 = 62.5; P < 0.001) and severity (df = 1; χ2 = 5649.6; P < 0.001) of BBR and significant differences between doses were also detected (df = 1; χ2 = 77.2; P < 0.001 for incidence and df = 1; χ2 = 580.9; P < 0.001 for severity). Reductions compared to the untreated control were 64 ± 3.4 and 35 ± 5.7% incidence and 85 ± 3.9 and 67 ± 4.0% severity for the high dose and the low dose treatments, respectively. A similar result was observed in Vineyard 2 (Fig. 1b), where treatments were able to significantly reduce BBR incidence by 56 ± 7.4 and 38 ± 7.5% (high dose and low dose, respectively; df = 1; χ2 = 48.9; P < 0.001), and a dose effect was evidenced (df = 1; χ2 = 5.92; P < 0.015). Both treatments reduced BBR severity (df = 1; χ2 = 1879.5; P < 0.001) by 78 ± 8.1 and 39 ± 7.5% compared to control (high dose and low dose, respectively), these reductions being significantly different between them (df = 1; χ2 = 696.5; P < 0.001). In Vineyard 3 (Fig. 1c), reductions were 38 ± 2.5 and 35 ± 5.7% incidence and 68 ± 2.0 and 59 ± 6.2% severity for the high dose and the low dose treatments, respectively. These reductions were significant (df = 1; χ2 = 36.1; P < 0.001 for incidence and df = 1; χ2 = 2479.0; P < 0.001 for severity) but the dose effect was only observed in severity control (df = 1; χ2 = 48.6; P < 0.001).
Incidence and severity of Botrytis bunch rot at harvest in three vineyards located in Catalonia (North-East Spain) during the 2011 growing season. The commercial plots cv. Macabeo were coded as Vineyard 1 (a), Vineyard 2 (b) and Vineyard 3 (c) and received two sprays at 80% flowering and pre-bunch closure with C. sake CPA-1 at 2.5 × 107 CFU g−1 plus FC at 50 g l−1 (High dose), with C. sake 1 × 107 CFU ml−1 + FC 25 g l−1 (Low dose) or were untreated (Control). An extra application was carried out in Vineyard 2 at pre-bunch closure and two weeks before harvest in Vineyard 1. Bunch rot was assessed over 50 bunches per replicate sample, six replicate samples were distributed in each treatment plot of 0.5 ha each. Mean values of incidence or severity linked by the same letter (upper or lower case, respectively) are not significantly different (p < 0.05) according to orthogonal contrasts analysis. Error bars represent SE
C. sake population dynamics on grapevine tissues
The quantification of C. sake populations on flowers and berries during the field experiments are summarised in Fig. 2. In Vineyard 1 (Fig. 2a), populations after the first application on grape flowers were around 4 log CFU g−1 for both C. sake concentrations that were applied. These populations decreased to approximately 2 log CFU g−1, similarly in both treatments, until pre-bunch closure application. After the second application, the high dose samples presented significantly higher populations than the low dose samples (3.4 ± 0.1 compared to 2.8 ± 0.1 log CFU g−1; F1,7 = 30.5; P = 0.0015). Then, populations decreased in parallel for both treatments until a third application at veraison (conducted after a hail storm). After this last spray, 2.4 ± 0.2 log CFU g−1 were quantified in the high dose samples, 0.7 ± 0.1 more than in the low dose, this difference being significant (F1,7 = 8.6; P = 0.026). Then populations decreased in parallel until harvest.
Population dynamics of Candida sake CPA-1 on flowers and berries during three vineyard experiments, located in Catalonia (North-East Spain) during the 2011 growing season. The commercial plots cv. Macabeo were coded as Vineyard 1 (a), Vineyard 2 (b) and Vineyard 3 (c) and received two sprays at 80% flowering and pre-bunch closure with C. sake CPA-1 at 2.5 × 107 CFU g−1 plus FC at 50 g l−1 (high dose), with C. sake 1 × 107 CFU ml−1 + FC 25 g l−1 (low dose). Spray applications (500 l ha−1) are marked with black arrows. Error bars represent SE
In Vineyard 2 (Fig. 2b), the concentration after the first spray was significantly higher in the high dose treatment compared to the low dose (4.6 and 3.5 log CFU g−1, respectively; F1,5 = 12.8; P = 0.023), and decreased to very low levels ten days after application. After the pre-bunch closure spray, populations in the low dose did not increase, due to the presence of fungicide residues in the sprayer, as will be discussed later in this paper. Nonetheless, populations increased by over 2 log CFU g−1 in the high dose samples, decreasing gradually after the next application. A second spray during the pre-bunch closure stage (13/07/2011) was carried out for both treatments, in order to ensure C. sake presence in the low dose blocks. After this application, populations were 3.1 ± 0.2 and 2.6 ± 0.1 log CFU g−1 (high dose and low dose, respectively), decreasing gradually until harvest and presenting similar levels (below log 1) in both treatments.
In Vineyard 3 (Fig. 2c), initial populations after the flowering spray were significantly different (5.2 and 4.4 log CFU g−1 in the high dose and low dose samples, respectively; F1,7 = 36.2; P < 0.001). One week later, populations were barely over the detection threshold (defined as 1 × 101 CFU g−1). However, populations were higher (approximately 2 log CFU g−1) on developing berries just before the pre-bunch closure application. After the pre-bunch closure spray, populations were significantly different between the high dose and low dose treatments (3.7 and 3.2 log CFU g−1, respectively; F1,7 = 10.5; P = 0.017) and then they decreased gradually until harvest, keeping at over 1 log CFU g−1.
In vitro compatibility of C. sake with pesticides commonly used in viticulture
The list of phytosanitary formulations tested, active ingredients, doses and their common use in vineyards are summarised in Table 1 with the degree of compatibility with C. sake that was observed. A total of 39 products were tested, including two wetting agents, three products against the grape berry moth Lobesia botrana, and 34 antifungal formulations against Botrytis, Aspergillus and black rots, powdery and downy mildews, anthracnose, ESCA and bacterial diseases. In general, most of the products or product combinations showed a high compatibility with C. sake cells except for four, all of them fungicides. One product showed intermediate compatibility (F26), since it significantly reduced C. sake populations by 0.34 ± 0.1 log (F1,5 = 42.6; P = 0.003). Among the fully incompatible formulations (F14, F29, F33), F14 was the only one containing one active ingredient (trifloxystrobin). The other incompatible products or combinations (F29 and F33) contained more than one active ingredient, which were also individually present in other compatible formulations, such as tebuconazole (F8), myclobutanil (F13 and F20), dinocap (F13), cymoxanil (F24, F25, F27 and F28) or Bordeaux mixture (F24 and F28).
In vivo compatibility of C. sake with pesticides commonly used in viticulture
The two fully incompatible products (excluding combination F33) were tested on grape berry surface in order to evaluate in vivo compatibility with C. sake (Table 2). Significant interactions were detected between treatment and TAA variables and, therefore, statistical analysis was conducted by comparing each product to the control individually. Only the F29 formulation had a significant effect on C. sake populations. Mean C. sake populations at the four TAA which were tested together were 0.36 ± 0.03 log units lower in the F29 treated berries (F1,31 = 70.1; P < 0.001). In the case of F14, the difference was only significant in one TAA. The analysis of the significant interaction showed a significant difference (F1,18 = 16.5; P < 0.001) between the control and the fungicide-treated samples of 0.23 ± 0.03 log units in the four days after fungicide application sampling.
Significant differences were also observed among TAAs in the F14 treatment (F2,23 = 14.5; P < 0.001). Overall, the 0 h samples presented significantly lower populations than the 24 h and four days samples analysis, according to the Tukey test.
In vivo compatibility of C. sake with B. thuringiensis var. kurstaki
In addition to the experiments with synthetic fungicides, the B. thuringiensis formulation was tested, although the in vitro experiment showed high compatibility, since a more complex competition on host tissues between both microorganisms could hypothetically occur (Fig. 3). The results evidenced no significant effect on C. sake populations that were co-inoculated with B. thuringiensis on grape clusters during seven days, compared to populations observed in clusters treated with C. sake alone. Populations in the CS and CS + BT samples were very similar during the experiment, ranging from 5.36 ± 0.08 log CFU g−1 to 5.77 ± 0.06 log CFU g−1. A significant increase in C. sake populations was observed between the 0 h and the 96 h samples. A similar increase was observed in B. thuringiensis populations, although it was not significant. Populations of the bacteria ranged between 4.04 ± 0.14 and 4.14 ± 0.02 log UFC g−1.
Population dynamics of Candida sake CPA-1 and Bacillus thuringiensis in joint culture on grape berry clusters. Clusters were treated with C. sake (5 × 107 CFU ml−1 + FC 50 g l−1) or with B. thuringiensis (5.55 × 106 CFU ml−1). CS C. sake CPA-1 alone, CS (BT) C. sake in joint culture with B. thuringiensis, BT Bacillus thuringiensis in joint culture with C. sake. Four replicates per treatment consisted of four grape clusters of five berries each. After treatment, clusters were incubated at 20 °C and 80% RH, and populations of the bacteria or yeast were recovered after 0, 24, 96 or 168 h of incubation. Error bars represent SE
Discussion
In the present study, C. sake CPA-1 has been applied in commercial field conditions, with the monitoring of its populations and the testing of its adaptation to commercial application by growers, who are usually working with a variety of phytosanitary products. To the best of our knowledge, this study represents the first published study that evaluates the effect of a BCA against BBR in vineyards at such a large scale.
The efficacy of C. sake plus FC that was observed in these field trials ranged from 38 ± 2.5 to 64 ± 3.4% of BBR incidence reduction, and 68 ± 2.0 to 85 ± 3.9% severity reduction for the high dose treatment. In the low dose treated plots, reductions ranged from 35 ± 5.7 to 38 ± 7.5% of incidence, and from 39 ± 17.5 to 68 ± 4.0% severity of the disease. Overall, reductions in both treatments were high and consistent among experimental vineyards, in considering a large-scale application context in two growing regions, with different vineyard management styles and application techniques, and even overcoming the effect of hail storm damage on maturing berries in Vineyard 1. The strategy of two applications that were focused on the early season, demonstrated to be effective in the context of North-East Spain vineyards and cv. Macabeo, confirming previous results on BBR epidemiology in the region (Calvo-Garrido et al. 2014c). Such a strategy provides an opportunity to reduce treatment cost, especially with a large-scale application, and can be complemented with more applications if needed, as happened after the aforementioned hail storm in Vineyard 1. On the whole, the dose effect was significant between treatments, although population levels in both treatments were generally similar. The high dose treatment reduced 16% incidence and 22% severity more than the low dose, indicating that a higher dose could substantially improve control with a reduction to very low BBR levels, which is a requirement for high-quality wines. However, we consider that the lower dose is also reliable in order to maintain acceptable BBR levels at harvest while minimising the cost of treatments. Consequently, these results validate the efficacy and the appropriateness of both doses, depending on grower requirements.
Similar BBR reductions had been previously demonstrated in field applications of C. sake plus FC in vineyards during 2009, 2010 and 2012 growing seasons, when severity reductions ranged from 82 to 90%, and incidence reductions were always over 63%, after two to six applications during the season (Calvo-Garrido et al. 2013, 2014b). Particularly, in the 2009 season, the C. sake treatment at 1 × 107 CFU ml−1 also showed lower incidence control, confirming the effect of a higher dose that was observed in the present work. The comparable reductions that were observed in both small- and large-scale experiments highlights the reliability of C. sake, a main constraint in dealing with biological control treatments in the field (Teixidó et al. 2010). Other studies have also shown BBR control with a variety of BCAs in vineyards, whether combined or not with natural products (Elmer et al. 2005; Meng and Tian 2009; Parry et al. 2011; Reglinski et al. 2010; Schilder et al. 2002; Zahavi et al. 2000), whereas the only published study on alternative strategies at a large scale against BBR, to the best of or knowledge, showed postharvest reductions of over 50%, compared to the control (Nigro et al. 2006). Thus, the consistent efficacy of C. sake treatments in commercial conditions has been similar or higher than other biological control examples and, in addition, vinification of treated grapes from Vineyard 1 showed no organoleptic alteration of elaborated wine (data not shown), highlighting its potential as a BCA product for future use in vineyards.
Population dynamics of C. sake were similar in all of the three vineyards, with concentrations after application of around 4 log CFU g−1 on flowers and around 3 log CFU g−1 on fruits, although populations in Vineyard 2 were always relatively lower. This variability could be due to the difference between the sprayers used and the different management techniques in the tested vineyards. However, this represents an overall good adaptability of the BCA to the different field site conditions and application machines. The importance of the application methodology was evidenced by the failed application of the low dose treatment in Vineyard 2, due to the poor cleaning of the sprayer after the previous trifloxystrobin treatment (incompatible active ingredient; Table 1). Fungicide residues on the tank and nozzles killed C. sake cells during the application. The effect of the spray system may have also accounted for the lower populations that were observed in these trials, compared to previous field experiments with C. sake, when populations on grapevine tissues were generally 2 log units higher (Calvo-Garrido et al. 2013, 2014b). The commercial tractor-driven sprayers applied treatments at a relatively high rate (300–400 l ha−1). Nonetheless, it is not comparable to manual application until runoff, which had been performed in previous experiments. Spray coverage was scored as moderate to good by using water-sensitive papers (data not shown), although the results were certainly irregular.
Taking into account the challenges derived from application under commercial field conditions, the present results of persistence and survival in the field, as well as the efficacy observed, these authors consider that the extrapolation of small-scale field experiments to a larger scale has been highly successful. In fact, this result represents an unexpected positive output for this kind of biocontrol study in commercial conditions, in which, compared to more controlled conditions, efficacy is generally reduced and more variable. The key issues in explaining this reliability might be: 1) the rusticity of C. sake itself, which is able to grow under a wide range of temperatures and water activity conditions (Teixidó et al. 1998), with enhanced osmotic tolerance during mass production (Cañamás et al. 2008), and 2) the combination of C. sake with a fatty acid-based NP, since the NP has a direct effect against B. cinerea, a priori less dependent of environmental fluctuations and which accounts for a substantial part of the overall treatment efficacy, whereas it also provides a favourable substrate for C. sake survival (Cañamás et al. 2011).
C. sake cells showed, in general, a high compatibility with almost all the phytosanitary products that were tested and B. thuringiensis, which represents a great advantage of this BCA regarding its application in the field. The compatibility of BCAs with fungicides and insecticides has often been evaluated for well-known BCA species such as Bacillus subtilis (Kumar et al. 2011), Clonostachys rosea (Reeh and Cutler 2013), Chaetomium globosum (Mol et al. 2014), and specially Trichoderma spp. A large amount of literature was published about the latter, testing its compatibility against a variety of synthetic fungicides and other substances (Ashwani et al. 2012; Bhandari and Kumar 2012; Garcia et al. 2007; Madhavi et al. 2011). The results of those cited studies show, in general, a good compatibility with most of the commonly used active ingredients with only exceptional cases of adverse effect on BCA cells, as observed for C. sake. Compatibility studies provide interesting information for future field application, allowing the interpretation of efficacy results in the case of incompatibility. Furthermore, the compatibility of BCA treatments with other control methods, including chemicals, represents an important topic in a context of combinational strategies to reduce biological control variability against fruit pathogens (Di Francesco and Mari 2014) and to extend the durability of fungicide control (Lima et al. 2008).
Direct contact with products in liquid solution was more harmful for C. sake than direct contact on the berry surface, since the same incompatible products in vitro, had a reduced effect on C. sake in the in vivo tests. Moreover, the deleterious effect of fungicide residues in the spray machinery in Vineyard 2 also corroborated the influence of direct contact in liquid solution. In the in vivo assay, although reductions of C. sake populations due to the presence of phytosanitary products on berry surface were significant, the magnitude of this reduction was limited, and might not have a practical implication in BCA survival and disease control. Therefore, compatibility with phytosanitary products was, in general, very good and a low impact of other vineyard treatments on C. sake treatments is foreseen, even if some precautions must be taken in terms of avoiding direct contact with molecules and also the proper cleaning of equipment. The combination with fungicides would allow IPM control strategies which should be better explored in further studies. These may include fungicide treatments against BBR or against other diseases, and applying between flowering and bunch closure in order to avoid residue presence at harvest. The C. sake treatments may also be combined with other BCAs or natural products with complementary modes of action. Microbial compounds produced by certain bacteria, as well as a variety of NPs (chitosan, inorganic salts or terpenes, for example), have direct action on B. cinerea and may represent effective curative treatments that could be combined with preventive applications of C. sake.
In conclusion, the efficacy of C. sake treatments in combination with the additive FC was confirmed at the larger scale within the present study, for three sites in two different climatic conditions, a variety of vineyard management styles, vine training systems, and application strategies. The BBR reduction observed was similar among the three studied examples and is coherent with previous small-scale trials, although C. sake populations tended to be lower. The consistency of control that was demonstrated under different situations, along with the high compatibility with phytosanitary products in vitro and in vivo, are important milestones in the potential future development of a BCA product for its application in IPM strategies against BBR in vineyards and they offer a new reliable biological control solution for growers.
References
Ashwani T, Rajesh K, Nandini G, Shailesh P (2012) Compatibility of Trichoderma viride for selected fungicides and botanicals. Int J Plant Pathol 3:89–94
Bhandari CP, Kumar J (2012) Compatibility of certain biopesticides Azadirachtin formulations and sodium bicarbonate with Trichoderma harzianum (Th-43). Int J Plant Prot 5:364–367
Calvo-Garrido C, Elmer PAG, Viñas I, Usall J, Bartra E, Teixidó N (2013) Biological control of botrytis bunch rot in organic wine grapes with the yeast antagonist Candida sake CPA-1. Plant Pathol 62:510–519
Calvo-Garrido C, Elmer PAG, Parry FJ, Vinas I, Usall J, Torres R, Agnew RH, Teixido N (2014a) Mode of action of a fatty acid-based natural product to control Botrytis cinerea in grapes. J Appl Microbiol 116:967–979
Calvo-Garrido C, Teixido N, Roudet J, Vinas I, Usall J, Fermaud M (2014b) Biological control of Botrytis bunch rot in Atlantic climate vineyards with Candida sake CPA-1 and its survival under limiting conditions of temperature and humidity. Biol Control 79:24–35
Calvo-Garrido C, Usall J, Viñas I, Elmer PAG, Cases E, Teixidó N (2014c) Potential secondary inoculum sources of Botrytis cinerea and their influence on bunch rot development in dry Mediterranean climate vineyards. Pest Man Sci 70:922–930
Calvo-Garrido C, Vinas I, Usall J, Rodriguez-Romera M, Ramos MC, Teixido N (2014d) Survival of the biological control agent Candida sake CPA-1 on grapes under the influence of abiotic factors. J Appl Microbiol 117:800–811
Cañamás TP, Viñas I, Usall J, Magan N, Solsona C, Teixidó N (2008) Impact of mild heat treatments on induction of thermotolerance in the biocontrol yeast Candida sake CPA-1 and viability after spray-drying. J Appl Microbiol 104:767–775
Cañamás TP, Viñas I, Torres R, Usall J, Solsona C, Teixidó N (2011) Field applications of improved formulations of Candida sake CPA-1 for control of Botrytis cinerea in grapes. Biol Control 56:150–158
Climatologia. L’Alt Penedés (2009a) http://static-m.meteo.cat/wordpressweb/wp-content/uploads/2014/11/13083422/AltPenedes.pdf. Accessed 10 Oct 2016
Climatologia. L’Urgell 1971-2000 (2009b) http://static-m.meteo.cat/wordpressweb/wp-content/uploads/2014/11/13083422/Urgell.pdf. Accessed 10 Oct 2016
Cus F, Cesnik HB, Bolta SV, Gregorcic A (2010) Pesticide residues and microbiological quality of bottled wines. Food Control 21:150–154
Di Francesco A, Mari M (2014) Use of biocontrol agents in combination with physical and chemical treatments: efficacy assessment. Stewart Postharvest Rev 10:2
Elmer PAG, Michailides TJ (2004) Epidemiology of Botrytis cinerea in orchard and vine crops. In: Elad Y, Williamson B, Tudzynski P, Delen N (eds) Botrytis: biology, pathology and control. Kuwer Academic Publishers, Dordrecht, pp 243–272
Elmer PAG, Reglinski T (2006) Biosuppression of Botrytis cinerea in grapes. Plant Pathol 55:155–177
Elmer PAG, Hoyte SM, Vanneste JL, Reglinski T, Wood PN, Parry FJ (2005) Biological control of fruit pathogens. In: Protection NZP (ed) Proceedings of a conference the New Zealand Plant Protection Society, Wellington, pp 47–54
Fillinger S, Walker A-S (2016) Chemical control and resistance management of Botrytis diseases. In: Fillinger S, Elad Y (eds) Botrytis—the fungus, the pathogen and its management in agricultural systems. Springer, Cham, pp 189–216
Freeman S, Minz D, Kolesnik I, Barbul O, Zveibil A, Maymon M, Nitzani Y, Kirshner B, Rav-David D, Bilu A, Dag A, Shafir S, Elad Y (2004) Trichoderma biocontrol of Colletotrichum acutatum and Botrytis cinerea and survival in strawberry. Eur J Plant Pathol 110:361–370
Fuster PMC (2006) Variedades de vid: registro de variedades comerciales, 2nd edn. Ministerio de Agricultura, Pesca y Alimentación, Madrid
Garcia M, Villamizar L, Cotes AM (2007) Compatibility of Trichoderma koningii with chemical fungicides. Bull IOBC/WPRS 30:441–445
Karabulut OA, Baykal N (2003) Biological control of postharvest diseases of peaches and nectarines by yeasts. J Phytopathol 151:130–134
Köhl J, Postma J, Nicot P, Ruocco M, Blum B (2011) Stepwise screening of microorganisms for commercial use in biological control of plant-pathogenic fungi and bacteria. Biol Control 57:1–12
Kumar KVK, Reddy MS, Kloepper JW, Yellareddygari SK, Lawrence KS, Zhou XG, Sudini H, Miller ME, Podile AR, Reddy ECS, Niranjana SR, Nayaka SC (2011) Plant growth-promoting activities of Bacillus subtilis MBI 600 (integral) and its compatibility with commonly used fungicides in rice sheath blight management. Int J Microbiol Res 3:120–130
Ky I, Lorrain B, Jourdes M, Pasquier G, Fermaud M, Geny L, Rey P, Doneche B, Teissedre PL (2012) Assessment of grey mould (Botrytis cinerea) impact on phenolic and sensory quality of Bordeaux grapes, musts and wines for two consecutive vintages. Aust J Grape Wine R 18:215–226
Lima G, Curtis Fd, Cicco Vd (2008) Interaction of microbial biocontrol agents and fungicides in the control of postharvest diseases. Stewart Postharvest Rev 4:4
Madhavi GB, Bhattiprolu SL, Reddy VB (2011) Compatibility of biocontrol agent Trichoderma viride with various pesticides. J Hortic Sci 6:71–73
Meng X, Tian S (2009) Effects of preharvest application of antagonistic yeast combined with chitosan on decay and quality of harvested table grape fruit. J Sci Food Agric 89:1838–1842
Mol B, Ramarethinam S, Murugesan NV (2014) Compatibility study of Chaetomium globosum with the fungicides (Ridomil, Blue Copper and score). Int J ChemTech Res 6:3019–3024
Nigro F, Schena L, Ligorio A, Pentimone I, Ippolito A, Salerno MG (2006) Control of table grape storage rots by pre-harvest applications of salts. Postharvest Biol Technol 42:142–149
Oliva J, Navarro S, Barba A, Navarro G, Salinas MR (1999) Effect of pesticide residues on the aromatic composition of red wines. J Agr Food Chem 47:2830–2836
Parry F, Elmer P, Wood P, Agnew R, Saunders J, Wurms K, Hoyte S, Chee A, Chee AA (2011) Developing new biologically-based products for control of botrytis bunch rot. Part 2: developing a new biologically-based product for late-season botrytis control: The BCA-L1 story. Wine Vitic J 26:73–78
Reeh KW, Cutler GC (2013) Laboratory efficacy and fungicide compatibility of Clonostachys rosea against Botrytis blight on lowbush blueberry. Can J Plant Sci 93:639–642
Reglinski T, Elmer PAG, Taylor JT, Wood PN, Hoyte SM (2010) Inhibition of Botrytis cinerea growth and suppression of botrytis bunch rot in grapes using chitosan. Plant Pathol 59:882–890
Romanazzi G, Smilanick JL, Feliziani E, Droby S (2016) Integrated management of postharvest gray mold on fruit crops. Postharvest Biol Tec 113:69–76
Schilder AMC, Gillett JM, Sysak RW, Wise JC (2002) Evaluation of environmentally friendly products for control of fungal diseases of grapes. In: Proceedings of the 10th international conference on cultivation technique and phytopathological problems in organic fruit-growing and viticulture, Weinsberg, Germany, 4–7 February 2002, pp 163–167
Teixidó N, Viñas I, Usall J, Sanchis V, Magan N (1998) Ecophysiological responses of the biocontrol yeast Candida sake to water, temperature and pH stress. J Appl Microbiol 84:192–200
Teixidó N, Usall J, Nunes C, Torres R, Abadias M, Vinas I (2010) Preharvest strategies to control postharvest diseases in fruits. In: Prusky D, Gullino ML (eds) Postharvest pathology. Plant pathology in the 21st century, vol 2. Springer, Dordrecht, pp 89–106
Teixidó N, Torres R, Viñas I, Abadias M, Usall J (2011) Biological control of postharvest diseases in fruit and vegetables. In: Lacroix C (ed) Protective cultures, antimicrobial metabolites and bacteriophages for food and beverage vol 3. Food Science, Technology and Nutrition, vol 201. Woodhead Publishing Limited, Cambridge, pp 364–402
Walker AS, Micoud A, Remuson F, Grosman J, Gredt M, Leroux P (2013) French vineyards provide information that opens ways for effective resistance management of Botrytis cinerea (grey mould). Pest Man Sci 69:667–678
Zahavi T, Cohen L, Weiss B, Schena L, Daus A, Kaplunov T, Zutkhi J, Ben-Arie R, Droby S (2000) Biological control of Botrytis, Aspergillus and Rhizopus rots on table and wine grapes in Israel. Postharvest Biol Tec 20:115–124
Acknowledgements
The authors are grateful to the University of Lleida for Carlos Calvo Garrido PhD grant and the organic production research project and to the European Union for their financial support through the INTERREG REDBIO Project. They are also grateful to vineyard owners (Joan Esteve, Manel Farré and Josep Maria Massana), technical field advisers (Antoni Abad, Rosa Bisa and Imma Pausas) and wineries (L’Olivera and Codorniu-Raventós) for their valuable help with field trials. A special acknowledgement also to Dr. Frederic Fabre for his help with statistical analysis.
Author information
Authors and Affiliations
Corresponding author
Additional information
Handling Editor: Fouad Daayf.
Rights and permissions
About this article
Cite this article
Garrido, C.C., Usall, J., Torres, R. et al. Effective control of Botrytis bunch rot in commercial vineyards by large-scale application of Candida sake CPA-1. BioControl 62, 161–173 (2017). https://doi.org/10.1007/s10526-017-9789-9
Received:
Accepted:
Published:
Issue Date:
DOI: https://doi.org/10.1007/s10526-017-9789-9